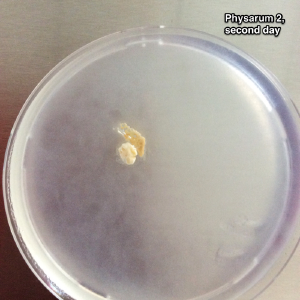
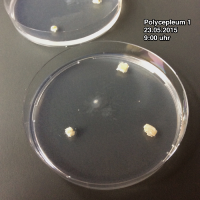
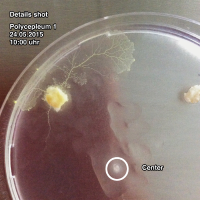
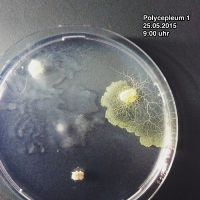
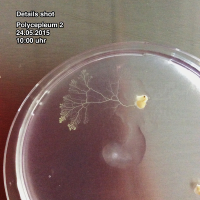

Hello Minimi!
My name is Smin Kim. I'm studying in Bauhaus University Weimar Master course, Media art and design. living and working in Weimar. Nice to see you here!
SNS
Start Bio Lab!
Introduction of Bio Lab
Professor Ursula Damm and Maria had the Introduction of Bio Lab in Marienstraße for students and teachers. And also new teacher Miga! in dataflow class joined. I decide to grow Physarum Polycephalum in Argar plate. First of all, i had to make enviroment for my minimi(Polycephalum) in Argar plate. (The Polycephalum can be cultured on 2% water argar, fed oat flakes) Argar should be solide (not liquid) so we had to wait until The argar is solidified. It took time (Approximately One day) Today I learned how to use the Bio lab. and Maria helped me a lot(thank you!) and i was so excited! 05.05.2015
*Good meterial for starting Bio Lab
Short guide Book "Techniques for Studying Bacteria and Fungi" from Carolina Biological Supply Company
you can check Website of Carolina
*Good Site for Euglena Community
you can check Tree of Life web project
*DIYSECT share from Maria!
you can check DIYSECT
*Synthetic aesthetics, Jane Calvert
you can check Synthetic aesthetics
After one week
My little minimi looks like dead... I guess that they are dead because of no water, and no nutrition on it on weekend. And they got a mole in a petry dish. So i try to make another Argar. (200ml, 2g argar powder) Now it getting to solid. 12.05.2015 16:00uhr
Try again Physarum
finally
Bio Game Project
Inspiration
This is NEW idea! it would be more easy understand, just imagine Euglenida instade of mushroom. (BIG Euglenida!)
- Max planck Institute for Development Biology
https://www.youtube.com/watch?v=1KIVW8cZQHU&list=PL75310AD28DB37A33
Phototaxis, directional swimming towards the light, is a widespread behaviour in marine plankton. About 80% of all marine invertebrates with a dispersing larval stage show positive phototaxis at the beginning of the dispersal phase. Following this positive phototactic stage, older larvae often become negatively phototactic. We study the mechanisms of both positive and negative phototaxis in Platynereis and other marine invertebrate larvae.
--Research Groups, Gáspár Jékely in Max planck Institute for Development Biology
<<For the first time in history, researchers at the Max Plankton Institute in the Netherlands have recorded piano music practised by a common water flea.
First light of the phenomenon was obtained using darkfield microscopy>>
Concept

For the first idea was simply interactive with Daphnia. I thought it looks great when daphnia be projected as a dog size! Actually they are too tiny when we want to play with them.
But in my experience, they are sensitive about temperature, quality of water, density, oxygen and light.
They are easy to die and easy to ill. So they need time to recover and take a rest. 10 minute is still short. But at least, not for human for Daphnia need some time! During 10 min breaks visitor could think about living creature as like as human, not LEGO or TOY they are.
Functional cycle

The relations beween subject and object are best shown by the diagram of the functional cycle. If this illustrates how the subject and the object are dovetailed into one another, to constitute a systematic whole.
If we further consider that a subject is related to the same or to different objects bt several functional cycle, we shall gain insight into the first Principle of Umwelt thory: all animals, from the simplest to the most complex, are fitted into their unique worlds with equal completeness. A simple world corresponds to a simple animal, a well-articulated world to a complex one. --Jakob von Uexküll, 11page, a Stroll Through the Worlds of Animals and Men
The whole rich world around the Tick shrinks and changes into a scanty framework consisting, in essence, of three receptor cues and three effector cues - her Umwelt. --Jakob von Uexküll, 12page, a Stroll Through the Worlds of Animals and Men
I was impressed by the text of Jakob von Uexküll. So i follow the same formet what he made”functional fied”. There is inner world and external world (real world). Inner world is left side of illustration which is central recepter(to see the moving Daphnia on the wall -> projection) and central effector(moving hands and legs). External world is right side of illustration which is recepter (they got signal from human’s moving) and effector (following the signal, change the color foils). for elements are all connected and keep go around.
color is detected by the camera, and processed with VVVV programming language, which further sends the signal through Arduino microcontroller to the servo motor in order to change the foil.
Color Experiments






Daphnia Pulex ,Magna , Monia are different species but same root.
Daphnia Pulex was positive to white, blue and green but negative to yellow and red.
Daphnia Magna was positive to green, yellow and red, and negative to blue and violet.
Monia has same behavior like Pulex but different react about orange and green.
Using their character, human can control their moving.
- color experiments daphnia (Video documentation)
<videoflash type=YouTube>2eRdbNO74Rw?list=PL75310AD28DB37A33</videoflash>
Poster print using silk screen
Working process
Programming
Summaery 2015
- Video documentation
<videoflash type=YouTube>_QypaarHD8k?list=PL75310AD28DB37A33</videoflash>